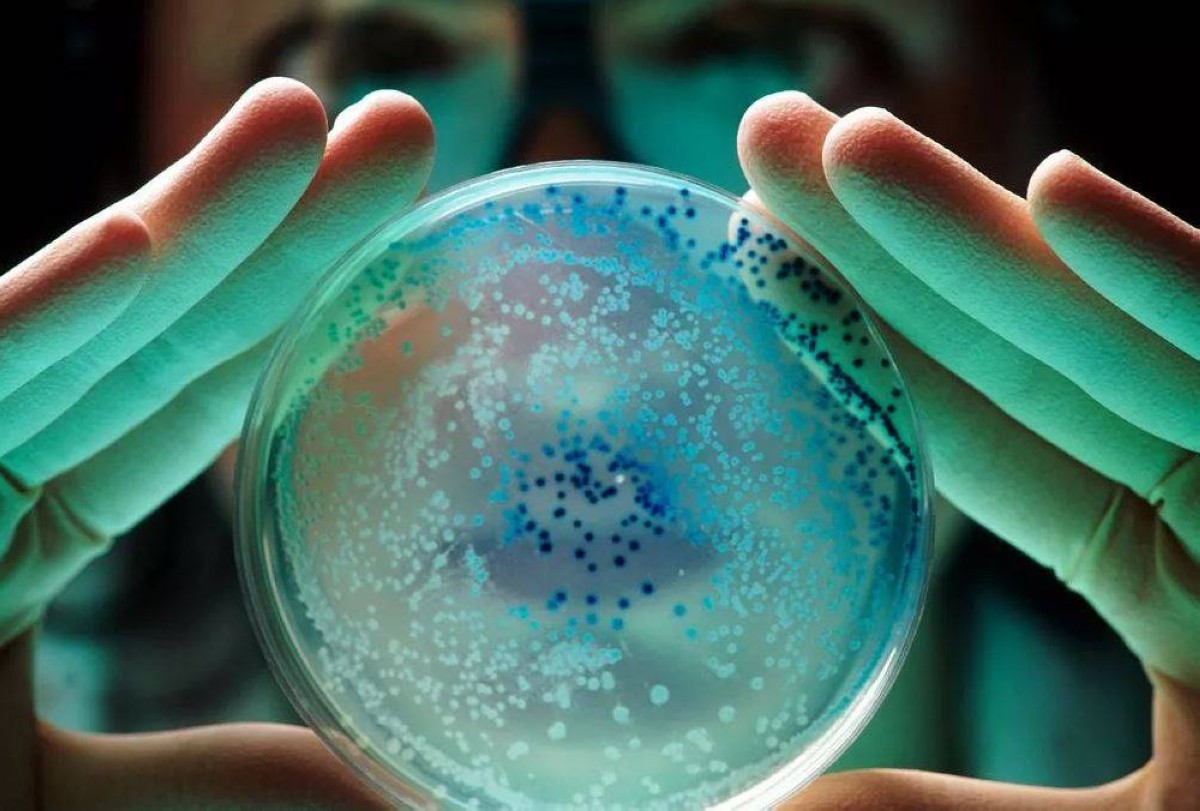

كشفت دراسة جديدة أجرتها شركة Money Supermarket أن مفاتيح السيارة تحتوي على كمية من البكتيريا تعادل أربعة أضعاف تلك الموجودة على الهاتف المحمول أو لوحة مفاتيح الكمبيوتر، ما يجعلها من أكثر العناصر قذارة التي نحملها معنا.
وعلى الرغم من النتائج المزعجة، فإن ثلث السائقين لم ينظفوا مفاتيح سياراتهم مطلقًا، على الرغم من أن ربعهم يمتلكونها منذ أكثر من خمس سنوات وفقًا لموقع MailOnline..
في حين أنه من المعروف بالفعل أن عجلة القيادة، وعصا ناقل الحركة، ولوحة القيادة هي حاضنات لتكاثر الجراثيم، إلا أن الخبراء يحذرون من أن المفاتيح نفسها تم إهمالها بشكل خطير، حسبما ذكرت صحيفة إكسبريس .
أجرى فريق الدراسة استطلاعًا على 2000 سائق سيارة حول عاداتهم في التنظيف وأنواع سياراتهم، كما أرسلوا عينات من أغراض مختلفة إلى مختبر، بما في ذلك الهواتف ولوحات المفاتيح ومقعد المرحاض - الذي لطالما اعتُبر من أكثر الأغراض المنزلية قذارةً.
نتائج صادمة
كانت النتائج صادمة، بلغ متوسط عدد البكتيريا على شاشات الهواتف المحمولة 66، بينما بلغ أعلى قليلاً على لوحات مفاتيح الحاسوب 68.
ومع ذلك، سجلت مفاتيح السيارة 241 درجة قذرة، أي ما يقرب من أربعة أضعاف درجة قذارة أي جهاز آخر.
وكما هو متوقع، احتل مقعد المرحاض المركز الأول بأعلى قراءة على الإطلاق عند 1100.
وقد قاد الدكتور جو لاتيمر، مدير شركة مايكروب كونسلتينج المحدودة وعالم الأحياء الدقيقة في جامعة سالفورد، هذا التحليل، واقترح أن مستويات البكتيريا على المفاتيح ربما لا تزال أقل من تقديراتها الحقيقية.
المكورات العنقودية
كانت البكتيريا الأكثر انتشارًا التي تم تحديدها على مفاتيح السيارة هي المكورات العنقودية البشروية - وهي حشرة توجد عادةً على الجلد ولكن من المعروف أنها تسبب عدوى تهدد الحياة في بيئات المستشفيات، وخاصة بعد الجراحة.
ومن المثير للقلق أن هذه البكتيريا أصبحت مقاومة بشكل متزايد للمضادات الحيوية، مما يثير مخاوف صحية إضافية.
وبينما كانت العديد من البكتيريا موجودة في الجلد، اكتشف الباحثون أيضًا آثارًا لبكتيريا الأمعاء على مجموعة واحدة على الأقل من المفاتيح.